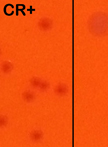

- Protocols
- Articles and Issues
- About
- Become a Reviewer
Past Issue in 2014
Volume: 4, Issue: 20
Immunology
Measurement of TACE Activity in Extracts from Cultured Cells
Microbiology
Synchronization of Saccharomyces cerevisiae Cells in G1 Phase of the Cell Cycle
Extraction and Purification of Mycobacterial Mycolic Acids
In vitro Assay for Cytidine Deaminase Activity of APOBEC3 Protein
Measuring UV-induced Mutagenesis at the CAN1 Locus in Saccharomyces cerevisiae
Design of a Transcription-based Secretion Activity Reporter (TSAR) for the Type III Secretion Apparatus of Shigella flexneri and Uses Thereof
Detection of the Secreted and Cytoplasmic Fractions of IpaB, IpaC and IpaD by Lysozyme Permeabilization
Severe Fever with Thrombocytopenia Syndrome Virus Infection of Cell Cultures
Molecular Biology
Expression and Purification of the Eukaryotic MBP-MOS1 Transposase from Sf21 Insect Cells
Neuroscience
Olfactory Habituation in Fasted Mice
Plant Science
Fluorescence Recovery after Photobleaching (FRAP) Assay to Measure the Dynamics of Fluorescence Tagged Proteins in Endoplasmic Reticulum Membranes of Plant Cells
Plastic Embedding of Arabidopsis Stem Sections
Seed Storage Reserve Analysis
A Protocol to Measure the Extent of Cell-to-cell Movement of RNA Viruses in Planta